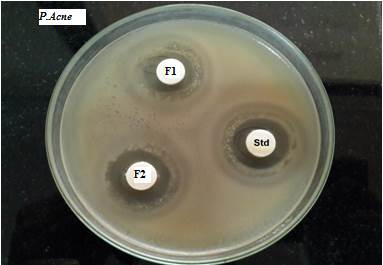
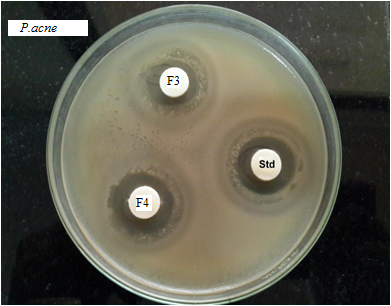
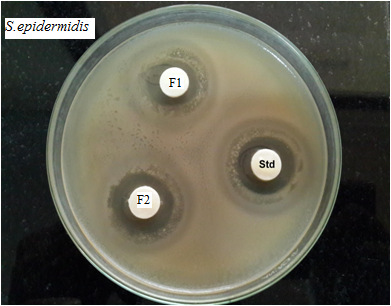

Mumbai Education Trust’s Institute of Pharmacy, MET Complex, Bandra Reclamation, Bandra (W), Mumbai 400050, India
Email: khushbushah590@gmail.com
Received: 05 May 2015, Revised and Accepted: 06 Jun 2015
ABSTRACT
Objective: The objective of the present study was to evaluate the anti-oxidant and anti-acne activities (in-vitro) of the formulated herbal gels.
Methods: Herbal extracts and volatile oils were prepared and procured. Preliminary screenings for the anti-oxidant and anti-acne activities (in-vitro) were carried out to select the suitable candidates for the preparation of anti-acne herbal gels. Gels were further evaluated for the activities.
Results: The herbal gel (F2) containing the herbal extracts (Azadirachtaindica, Ocmium sanctum, Curcuma longa) each (1%) and volatile oils (Melaleuca alternifoliae, Salviaesclareae and Citrus sinensis) each (0.05%) showed maximum anti-oxidant activity (IC50 value 0.407 mg) amongst all four gels. Significant Anti-acne activity against P. acne and S. epidermidis was showed by F2 when compared with the marketed synthetic gel (Clindac gel).
Conclusion: The study proves that the herbal actives used in the formulation have promising anti-oxidant and anti-acne activity.
Keywords: Herbal extracts, Volatile oils, Gelling agents, Anti-oxidant activity and anti-acne activity.
INTRODUCTION
Acne is found be the universal skin disorder. The main target for the treatment of acne is to-
The conventional therapies used for acne have following problems such as dryness of skin, dermatitis, darkening of skin, recurrence after withdrawal and the excessive use of antibiotics for longer period develops resistance against P. acne and S. epidermidis, and results in adverse effects like gram-negative folliculitis [1, 2].
The herbal gel is formulated by using natural gelling agents, herbal extracts and volatile oils. This gel provides multi-therapeutic effect with negligible adverse effect and has similar rheological properties of gel. Hence they are preferred over synthetic ones [3]. The potential candidates showing anti-acne activity are Azadirachtaindica, Ocmium sanctum, Curcuma longa, Melaleuca alternifoliae, Salviaesclareae and Citrus sinensis. Hence these plants were selected along with Aloe vera mucilage powder 200 X (gelling agent) and carbopol 940 (viscosity modifier) for the formulation [4].
Table 1: List of herbs used with their specification
| Herbs | Part of herb | Extraction method | Solvent | Phyto-constituents |
| Neem | Leaves | Solvent extraction | Methanol | Quercetin |
| Tulsi | Leaves | Maceration | Methanol | Eugenol |
| Turmeric | Rhizome | Solvent extraction | Acetone | Curcumin |
Table 2: List of volatile oils used with their specification
| Volatile oils | Part of herb | Phyto-constituents |
| Tea tree | Leaves | Terpinen-4-ol |
| Clary sage | Flowering stem | Linayl acetate, linalool, α-Terpineol |
| Orange | Fresh peel | D-limonine, linalool |
Materials and Methods
Neem leaf powder, turmeric rhizome powder, tulsi leaf powder, euxyl 9010, tea tree oil, orange oil, clary sage oil, Aloe vera mucilage 200X powder was procured as gift sample. Ascorbic acid, carbopol 940, DPPH (2, 2-Diphenyl-1 picrylhydrazy) were obtained from Merck Pvt. Ltd, Mumbai. Anti-acne activity studies were conducted at Micro Bio Laboratory. All reagents used were of analytical grade.
Preparation of herbal extracts
The methanolic tulsi extract was prepared by maceration method. The methanolic neem and turmeric acetone extract were prepared by soxhlet extraction method.
Preparation of herbal gel
Step 1: Preparation of gel base
Required quantity of Aloe vera powder (200 X) was weighed and dissolved in water (100 gm) with continuous stirring using mechanical stirrer at 1000rpm (Remi motor RQT-127 HP1/8) at the temperature between 60-80 oC for 1hour in the reactor vessel (SS316). Gel forming polymers was added in various proportions to the solution (table 3). The pH of the solution was adjusted to 6.0-6.4 by addition of triethanolamine. Euxyl P. E. 9010 was used as preservative. All the gel bases were allowed to equilibrate for 12 hours at room temperature.
Table 3: Composition of herbal anti-acne gel
| S. No. | Formulation codes Ingredients (gm) | F1 | F2 | F3 | F4 |
| Step1:Gelbase | |||||
| Aloevera20 0Xpowder | 0.4 | 0.4 | 0.5 | 0.5 | |
| Carbopol-94 0 | 0.5 | 0.4 | 0.4 | 0.5 | |
| Triethanolamine | 0.1 | 0.1 | 0.1 | 0.1 | |
| EuxylP. E.9010 | 0.6 | 0.6 | 0.6 | 0.6 | |
| Distilledwaterupto | 10 0 | 10 0 | 10 0 | 10 0 | |
| Step2:Formulationofherbalgel | |||||
| Neemextract | 1 | 1 | 1 | 1 | |
| Turmericextract | 1 | 1 | 1 | 1 | |
| Tulsiextract | 1 | 1 | 1 | 1 | |
| Teatreeoil | 0.05 | 0.05 | 0.05 | 0.05 | |
| Orangeoil | 0.05 | 0.05 | 0.05 | 0.05 | |
| Clarysageoil | 0.05 | 0.05 | 0.05 | 0.05 | |
| Gelbase | 10 0 | 10 0 | 10 0 | 10 0 |
Step 2: Preparation of the formulation
The herbal extracts (1% each) and volatile oils (0.05% each) were added with continuous stirring using mechanical stirrer at 1000rpm (Remi motor RQT-127 HP1/8)to different gel bases till the uniform dispersion of the ingredients was achieved.
All these batches were allowed to equilibrate for 24 hours at room temperature. The prepared gel was filled and stored ina wide mouth polypropylene container.
Biological evaluation
0.012 gm of DPPH was weighed and dissolved in 90 ml of methanol and volume was made up to 100 ml.
10 mg of ascorbic acid was weighed and dissolved in 100 ml of distilled water in an amber colored volumetric flask. The solution was vortexed on a cyclomixer and used as standard.
c) Sample preparation
The stock solution of 1 gm of sample in 10 ml of methanol was prepared. The solution was sonicated for 10 minsand vortexed. The clear methanolic solution obtained was used for assay.
One month trial version of Graph Pad Prim 6.5 software was used to plot graphs and for the calculation of IC50 values by point to point curve method [5].
The petri plates were washed thoroughly and sterilized in hot air oven at 160 °C for 1 ½ hours. 20 ml of sterile molten antibiotic assay medium was seeded by micro-organism; it was poured aseptically in sterile plate and allowed to solidify at room temperature. After the solidification of soft agar, sterile disc impregnated with the gel sample were placed over the solidified agar plate.
The plates were left for 10 min’s at room temperature to allow the diffusion of gel and incubated at 37 °C for 24 hours for S. epidermidis and 48 hrs for P. acne under anaerobic conditions. The plates were then observed for the zone of inhibition (mm). The zone of inhibition was calculated by measuring the diameter of the zone including the well diameter. Readings were taken in triplicates (in three different directions) and the average values were calculated
Measurement of zone of inhibition
The zone of inhibition for each sample was observed, measured and expressed in mm. From this the activity index (A. I.) and Percent Inhibition (P. I.) were calculated for all oils and extracts using the following formula.
A. I = Mean zone of inhibition of each formulation
Zone of inhibition obtained for standard
P. I. = Activity index x 100 [2, 6]
RESULTS
| Concentration (mcg/ml) | % Inhibition of DPPH radical | Standard deviation |
| 0 | 0 | 0 |
| 10 | 11.234 | 0.58845 |
| 20 | 23.833 | 0.422383 |
| 30 | 36.83 | 0.29964 |
| 40 | 50.16 | 0.541516 |
| 50 | 71.55 | 0.277978 |
| 60 | 81.92 | 0.305054 |
| 70 | 87.38 | 1.036101 |
| 80 | 94.69 | 0.925993 |
| 90 | 95.49 | 0.981949 |
Table 5: Anti-oxidant activity of herbal gel formulations
| Concentration mg/ml) | %Inhibition of F1 gel±SD | % Inhibition of F2 gel±SD | % Inhibition of F3 gel±SD | % Inhibition of F4 gel±SD |
| 0 | 0 | 0 | 0 | 0 |
| 0.5 | 60.54±1.24 | 61.47±2.02 | 61.08±1.24 | 61.27±1.24 |
| 1 | 75.33±1.19 | 77.48±1.02 | 75.87±1.19 | 75.87±1.19 |
| 1.5 | 80.61±0.87 | 81.68±0.94 | 80.61±0.76 | 80.61±0.76 |
| 2 | 82.28±0.94 | 82.82±0.94 | 82.28±0.94 | 82.28±0.94 |
| 2.5 | 83.52±0.92 | 84.05±0.92 | 83.46±0.90 | 83.25±0.077 |

Fig. 1: Plot of % inhibition of DPPH v/s concentration of ascorbic acid
From (fig. 2)
The IC50 value of F1 was found to be 0.413 mg/ml
The IC50 value of F2 was found to be 0.407 mg/ml
The IC50 value of F3 was found to be 0.409 mg/ml
The IC50 value of F4 was found to be 0.408 mg/ml

Fig. 2: Plot of % inhibition of DPPH v/s concentration of herbal gel formulations
The anti-acne activity of the herbal gel formulations showed significant and promising activity against P. acne and S. epidermidis in comparison with the marketed synthetic gel (Clindac gel).

Fig. 3: Anti-acne activity against P. acne

Fig. 4: Anti-acne activity against S. epidermidis
Table 6: Anti-acne activity of optimized formulations (in vitro)
| S. No. | Formulation codes | Zone of inhibition (mm)±SD (n=3) | |
| P.acne | S.epidermidis | ||
| 1 | F1 | 19.2±0.05 | 19.3±0.05 |
| 2 | F2 | 19.7±0.05 | 19.8±0.05 |
| 3 | F3 | 19.5±0.05 | 19.7±0.05 |
| 4 | F4 | 19.6±0.05 | 19.5±0.05 |
| 5 | Marketed formulation | 20±0.05 | 20±0.05 |
Table 7: Percentage inhibition of optimized formulations
| S. No. | Formulation codes | P.acne | S.epidermidis | ||
| A.I. | P.I. (%) | A.I. | P.I. (%) | ||
| 1 | F1 | 0.96 | 96 | 0.965 | 96.5 |
| 2 | F2 | 0.985 | 98.5 | 0.99 | 99 |
| 3 | F3 | 0.97 | 97 | 0.985 | 98.5 |
| 4 | F4 | 0.98 | 98 | 0.97 | 97 |
| 5 | Marketed formulation | 1 | 100 | 1 | 100 |

Fig. 5: Anti-acne activity profile of optimized formulations (in vitro).
DISCUSSION
The F2 gel containing Aloe vera mucilage powder (0.4%) and carbomer (0.4%) shows higher release of herbal actives. It showed maximum anti-oxidant (IC50 value 0.407 mg) amongst the four gels. Significant anti-acne activity against P. acne and S. epidermidis was showed by F2 when compared with the marketed synthetic gel (Clindac gel).
CONCLUSION
The studies conclude that all four herbal gels showed anti-oxidant and anti-acne activity. In addition to the promising biological activity it was also observed that the varying concentrations of gelling agent played an important role in the release of the activephyto-constituents.
ACKNOWLEDGEMENT
We are thankful to Micro Bio Laboratory for providing facilities to conduct anti-acne activity. We would like to sincerely thank the Management, Principal and Director of Mumbai Education Trust’s Institute of Pharmacy for providing us the infrastructure for carrying out the research work. Our sincere thanks to Gayatri Herbals Pvt Ltd, Kamal Arochem for providing gift samples.
CONFLICT OF INTERESTS
Declared None
REFERENCES